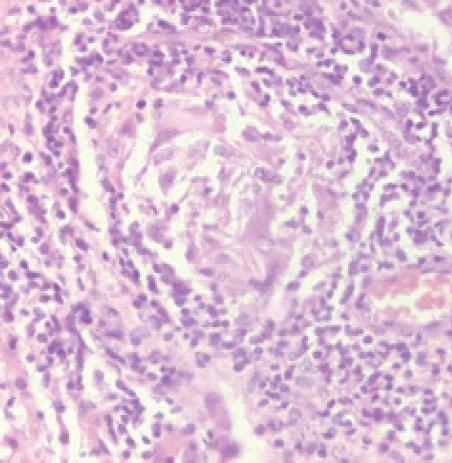
https://cdn.ncbi.nlm.nih.gov/pmc/blobs/281e/9831236/4e50d06e11c4/JOCR-12-106-g003.jpg

复合性背根神经节:一种罕见的结核病伪装表现。
Compound Dorsal Ganglion: A Rare Masquerade of Tuberculosis.
作者信息
Mukkamalla Sai Kumar Reddy, Vijitha B, Reddy M Divya Prasad, Rao H Umanatha
机构信息
Department of Orthopedics, Viswabharathi Medical College and Hospital, Kurnool, Andhra Pradesh, India.
出版信息
J Orthop Case Rep. 2022 Aug;12(8):106-109. doi: 10.13107/jocr.2022.v12.i08.2986.
INTRODUCTION
Compound dorsal ganglion of tubercular etiology involving the dorsum aspect of wrist is a rare entity. It is very rarely seen lately, due to early diagnosis and effective treatment regimen and this case is probably the first to be reported involving the dorsum aspect of wrist.
CASE REPORT
This case report presents a 54-year-old male patient presented to us complaints of swelling and pain in dorsum of hand and wrist for 6 months. On examination, we found multiple swellings on Rt. dorsum of hand and dorsal aspect of wrist restriction of movements at wrist. After thorough clinical and radiological evaluation, patient has been posted for excision biopsy and confirmed as compound dorsal ganglion.
CONCLUSION
Compound dorsal ganglion is a disease with great diagnostic challenge due to its masquerade clinical presentation and confirmed by histopathological examination. Early diagnosis, complete debulking, and antitubercular therapy prevent further spread of disease and improves the patient functionally.
引言
结核病因导致的累及腕背部的复合性腱鞘囊肿是一种罕见的病症。由于早期诊断和有效的治疗方案,近年来已很少见,而该病例可能是首例报道的累及腕背部的病例。
病例报告
本病例报告介绍了一名54岁男性患者,因手部和腕背部肿胀疼痛6个月前来就诊。检查时,我们发现右手背和腕背部有多个肿胀,腕部活动受限。经过全面的临床和放射学评估,患者接受了切除活检,确诊为复合性腱鞘囊肿。
结论
复合性腱鞘囊肿因其伪装的临床表现而具有很大的诊断挑战性,需通过组织病理学检查确诊。早期诊断、彻底切除病灶和抗结核治疗可防止疾病进一步扩散,并改善患者的功能。